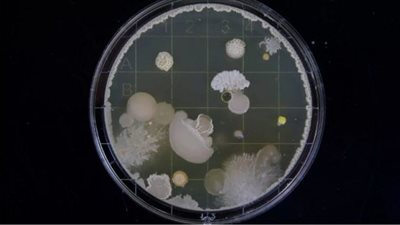
txt

حبس شخص بتهمة سرقة المواد البترولية المدعمة

أمرت جهات التحقيق بالقليوبية ، بحبس شخص يقوم بسرقة المواد البترولية المدعمة وإقامة طلمبة لضخ المواد البترولية وإقامة تنكات تحت الأرض 4 أيام علي ذمة التحقيقات .
حبس شخص بتهمة سرقة المواد البترولية المدعمة
وتأتي تلك الخطوة في إطار متابعة ومراقبة الأسواق للاطمئنان على الحالة التموينية وتوافر السلع وضبط الأسعار واتخاذ الاجراءات القانونية ضد المخالفين تنفيذا لتعليمات الدكتور علي المصيلحي وزير التموين والتجارة الداخلية واللواء عبدالحميد الهجان محافظ القليوبية وتنفيذا لتوجيهات عيد عبد الله وكيل وزارة التموين بالقليوبية بتشديد الرقابة على السلع المدعمه وخاصة المواد البتروليه
وقامت إدارة تموين شبين القناطر برئاسة مدير الإدارة ومأموري الضبط القضائي وذلك بعد ورود معلومات بوجود احد الاشخاص بناحيه مركز شبين القناطر يقوم بالاتجار بالمواد البترولية المدعمة وإقامة طلمبة لضخ المواد البترولية وتنكات تحت الأرض وقد تم التوجه للمكان المذكور وتم ضبط أحد الأشخاص يقوم بالاتجار في المواد البترولية بدون ترخيص وإقامة طلمبه ضخ للبنزين والسولار وإقامة تنكات تحت الأرض.
تم التحفظ بحوزته على كميات من المواد البترولية وعليه تم التحفظ علي الكميات المضبوطه بعد قياسها وهي عباره عن الآتي ٢٥٠٠ لتر بنزين ٨٠، ٣٠٠٠ لتر سولار، تحرر محضر بالواقعة واخطرت النيابه العامة للتحقيق.
في سياق آخر أحالت هيئة الدائرة السابعة، بمحكمة جنايات شبرا الخيمة بمحافظة القليوبية ، أوراق سائق إلى فضيلة مفتي الجمهورية لإبداء الرأي الشرعي فى إعدامه، وتأجيل محاكمة شقيقيه لاتهامهم بقتل شخص وإصابة شقيقه لخلافات بينهم فى القناطر الخيرية.
تفاصيل إحالة سائق إلي المفتي بسبب قتل شخص
وعقدت الجلسة برئاسة المستشار أشرف فتحي حلمي، وعضوية المستشارين محمد عامر حلمي الشاهد، وتامر عادل حجازي، وعمرو محمد عبد الوهاب مخلوف، وأمانة سر عاصم طايل.
وكشف أمر الإحالة فى القضية رقم 17275 لسنة 2022جنايات مركز القناطر الخيرية والمقيدة برقم 2850 لسنة 2022كلي جنوب بنها، أنه في 9/7/2022، قام ناجي معروف إبراهيم 26 سنة وشهرته دقدق، سائق ونش، ومروان معروف إبراهيم 19 سنة ميكانيكي، وأدهم معروف إبراهيم، مقيمين شارع المرور بقرية شلقان فى القناطر الخيرية، قتلوا عمدًا المجني عليه محمد شعبان محمد عبد الرحمن عن سبق إصرار، وترصد إثر خلاف سابق فيما إنفاذ مشروعهم الإجرامي المتفق عليه فأعدوا له سلاحًا ناريًا - فرد خرطوش وذخيرته وسلاحا أبيضا، وتوجهوا لمسكنه لإتيان فعلتهم المشؤومة فلم يجدوه به فقبعوا هم الثلاثة بمحل أيقنوا مروره هو وعشيرته به وما أن لاح لهم المجني عليه المار بيانه حتى أطلق المتهم الأول صوبة عيارًا ناريًا من فرد الخرطوش سالف الذكر قاصدًا من ذلك إزهاق روحه فأحدث إصابته المبينة بتقرير الصفة التشريحية الخاص به المرفق بالأوراق أودت بحياته إبان تواجد المتهمين الثاني والثالث على مسرح الجريمة للشد من ازره على النحو المبين بالأوراق.
وبين أمر الإحالة ان المتهمين شرعوا في قتل المجني عليه أحمد شعبان محمد عبد الرحمن عن سبق إصرار وترصد إذ وبفراغ المتهم الأول من فعلته محل الاتهام الأول وإبان تواجد المتهمين الثاني والثالث على مسرح الجريمة للشد من ازره أطلق هو صوبه عيارًا ناريًا من ذات السلاح الناري المُشار إليه بالاتهام الأول قاصدًا من ذلك إزهاق روحه فأحدث إصابته المبينة بالتقرير الطبي الخاص به المرفق بالأوراق، إلا أنه قد خاب أثر جريمته لسبب لا دخل لإرادته به وهو مداركة المجني عليه لما أصابه بالعلاج على النحو المبين بالأوراق.
وجاء أمر الإحالة ان المتهمين حازوا وأحرزوا بغير ترخيص سلاحًا ناريًا غير مششخن - فرد خرطوش على النحو المبين بالأوراق، كما حازوا وأحرزوا بغير ترخيص طلقات خرطوش مما تستخدم على السلاح الناري مواد الاتهام.

تابعوا آخر أخبار بوابة الوفد الإلكترونية عبر نبض
تابعوا آخر أخبار بوابة الوفد الإلكترونية عبر نبض